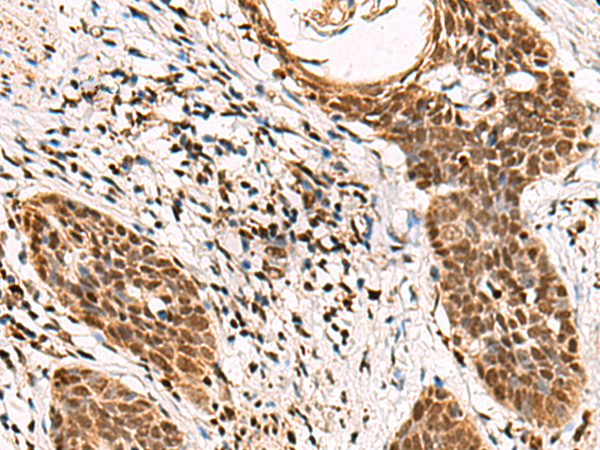

|
Background: |
This gene encodes the GA-binding protein transcription factor, beta subunit. This protein forms a tetrameric complex with the alpha subunit, and stimulates transcription of target genes. The encoded protein may be involved in activation of cytochrome oxidase expression and nuclear control of mitochondrial function. The crystal structure of a similar protein in mouse has been resolved as a ternary protein complex. Multiple transcript variants encoding distinct isoforms have been identified for this gene. |
|
Applications: |
ELISA, WB |
|
Name of antibody: |
GABPB1 |
|
Immunogen: |
Synthetic peptide of human GABPB1 |
|
Full name: |
GA binding protein transcription factor subunit beta 1 |
|
Synonyms: |
E4TF1; GABPB; BABPB2; E4TF1B; GABPB2; NRF2B1; NRF2B2; GABPB-1; E4TF1-47; E4TF1-53 |
|
SwissProt: |
Q06547 |
|
ELISA Recommended dilution: |
5000-10000 |
|
WB Predicted band size: |
42 kDa |
|
WB Positive control: |
Mouse lung tissue, Mouse thymus tissue, Jurkat cell lysates |
|
WB Recommended dilution: |
200-1000 |

購(gòu)物車
幫助
021-54845833/15800441009
